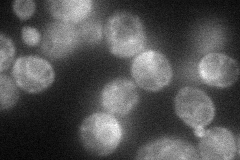
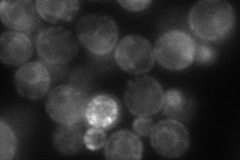

View description
Peroxisomal integral membrane peroxin, involved in the regulation of peroxisomal size, number and distribution; genetic interactions suggest that Pex28p and Pex29p act at steps upstream of those mediated by Pex30p, Pex31p, and Pex32p
Localization:
Intensity:
Fold change:
Significance:
-
C’ GFP library in SD

below threshold15.52 -
N' NOP1pr-GFP in SD
ER51.8247 -
N' TEF2pr-mCherry in SD
ER,punctate63.0412 -
N' NATIVEpr-GFP in SD

ambiguous20.5397 -
N' TEF2pr-VC and Cyto-VN in SD

cytosol31.35 -
C’ GFP library in SD+DTT

cytosol17.551.13No -
C’ GFP library in SD+H2O2

cytosol15.981.02No -
C’ GFP library in Starvation Media

cytosol17.451.12No -
C’ GFP library on the background of Pup2-DaMP

N/A -
C’ GFP library on the background of CCT mutant

N/A0N/AYes
